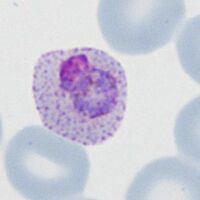

Red cell size: Difference between revisions
From haematologyetc.co.uk
No edit summary |
No edit summary |
||
| Line 35: | Line 35: | ||
<gallery mode="nolines" widths="200px" heights="220px" > | <gallery mode="nolines" widths="200px" heights="220px" > | ||
File:3SizePMET.jpg|link={{filepath:|3SizePMET.jpg}} | File:3SizePMET.jpg|A|link={{filepath:|3SizePMET.jpg}} | ||
File:4SizePFLT.jpg|link={{filepath:4SizePFLT.jpg}} | File:4SizePFLT.jpg|B|link={{filepath:4SizePFLT.jpg}} | ||
</gallery> | </gallery> | ||
Revision as of 21:28, 24 March 2024
Navigation
Go Back
| How is red cell size and shape affected as malaria develops?
SMALL ROUND RED CELLS P.malariae: The red cells in this species remain round and are often small in size The early (A) and late trophozoites (B) shown in this image each lie within round erythrocytes with reduced size. RED CELLS WITH UNCHANGED SIZE AND SHAPE P.faliparum Red cell size and shape is generally unchanged although they may become crenated
The early (A) trophozoites lie within red cells that do not change size or shape, at later development (B) they may remain unchanged or acquire subtle crenation. P.ovale The rings are larger and more robust than in P.falciparun, and they enlarge further during parasite development although in this species the characteristic ring appearance can often still be distinguished even late in development. Note that red cells become enlarged and distorted (typically elongation and fimbriation) with characteristic James' dots. P.malariae The rings are small but generally appear more robust than P.falciparum, the parasites become more solid often losing the central digestive vacuole and may become angular or extend as a band across the cells. Red cells are not enlarged or distorted and are often reduced in size as they mature in this species
these changes are. illustrated for. early and. late trophozoite below early trophozoites fsmall or normal p..emalariae round p..efalciparum round normal or. enlarged p..eovale may. become ovoid generally enlarged p..evivax may. become irregular late trophozoites file msi2.ejpg.
|